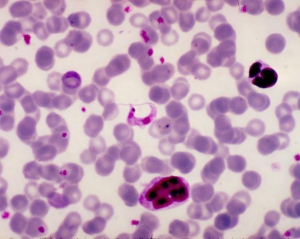

Болезнь Шагаса вызывается паразитами, которых разносят кровососущие насекомые, сообщает The New York Times. Научное издание PLoS Neglected Tropical Diseases назвало ее "новым СПИДом обеих Америк".
Как и у СПИДа, у болезни Шагаса долгий инкубационный период, она трудноизлечима или даже неизлечима. Может передаваться при переливании крови или от матери к ребенку.
Болезнью Шагаса заражены до 8 млн человек, преимущественно жители Боливии, Мексики, Колумбии и Центральной Америки. Более 300 тыс. носителей проживают в США.
ЧИТАЙТЕ ТАКЖЕ: В США будут выпускать препарат, снижающий риск заражения ВИЧ
Примерно у четверти жертв сердце или кишечник постепенно патологически разрастаются, что может привести к скоропостижной смерти. Существующие лекарства эффективны лишь на ранней стадии болезни.
Комментарии